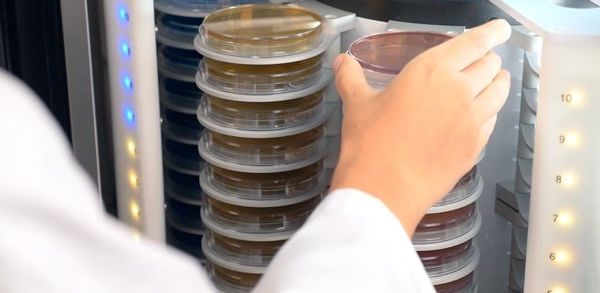

Мы приняли вашу заявку, свяжемся с вами в ближайшее время.

История
Часть товаров из корзины будет перемещена в статус отложенных и не сможет быть оформлена для заказа, если вы продолжите работу в данном регионе
История

История
История
 Актуальная проблема микробиологических исследований — поиск решений по сокращению временных затрат на полученине результатов. Выявление и подсчет колоний микроорганизмов традиционными (классическими методами), в основе которого лежит культивирование колоний на чашках Петри имеет ряд преимуществ, к которым можно отнести: невысокую стоимость анализа, доступность для работы любой микробиологической лаборатории в различных областях применения, таких как пищевая, фармацевтическая, косметическая промышленность, ветеринария и т.д. Классический метод анализа рекомендован основными стандартами, такими как ISO, FDA или GLP. Основные недостатки классического метода, к которым можно отнести: длительное время получения результата, отсутствие прослеживаемости, а также человеческий фактор требуют применения экспресс-методов с высокими эксплуатационными расходами.
Актуальная проблема микробиологических исследований — поиск решений по сокращению временных затрат на полученине результатов. Выявление и подсчет колоний микроорганизмов традиционными (классическими методами), в основе которого лежит культивирование колоний на чашках Петри имеет ряд преимуществ, к которым можно отнести: невысокую стоимость анализа, доступность для работы любой микробиологической лаборатории в различных областях применения, таких как пищевая, фармацевтическая, косметическая промышленность, ветеринария и т.д. Классический метод анализа рекомендован основными стандартами, такими как ISO, FDA или GLP. Основные недостатки классического метода, к которым можно отнести: длительное время получения результата, отсутствие прослеживаемости, а также человеческий фактор требуют применения экспресс-методов с высокими эксплуатационными расходами.
Компания Диаэм имеет инновационное решение, сочетающее традиционный и экспресс-методы автоматизации микробиологического анализа. Данное решение позволяет проводить инкубирование, анализ и подсчет колоний микроорганизмов в режиме реального времени на базе системы ScanStation.
Линейка оборудования серии ScanStation представлена компанией Interisence, которая уже более 48 лет является одной из передовых производителей микробиологического оборудования для автоматизации, пробоподготовки, анализа и учета микробиологических анализов.
Автоматическая система ScanStation — полностью роботизирована ипозволяет проводить инкубацию, детекцию и подсчет колоний на агаризованных средах на чашках Петри различного диаметра от 55 до 90 мм в режиме реального времени. Полный цикл исследования ScanStation в режиме реального времени составляет 24 ч, предварительные результаты доступны по истечении первых 8 часов.
 |
|
|
Принцип работы автоматизированной системы инкубации ScanStation
|
|
ScanStation оснащен вращающимся инкубатором (термостатом) карусельного типа, роботизированным захватом (рукой) и высокочувствительным прибором для подсчета колоний. В инкубаторе с точно регулируемой температурой могут инкубируоваться от 100 до 300 чашек Петри в зависимости от модели прибора.
Через каждые 30 мин автоматический захват (рука) забирает чашки Петри из термостата и помещает в счетчик колоний, где происходит фотозахват изображений каждой чашки Петри. Счетчик колоний, оснащен высокочувствительной 5 Мп Ultra-HD камерой, которая позволяет обнаруживать колонии, в самом начале их роста, до того, как может произойти их объединение или склеивание между собой, при этом фильтруются блики, артефакты, на полученных снимках. Колонии считаются в процессе инкубирования автоматически в момент их появления, одновременно происходит видеозапись роста бактерий в реальном времени. Эта функция дает информацию о почасовом росте бактерий, результат которого можно прогнозировать и можно отслеживать полученные данные. Результаты исследования сжимаются в архив и остаются доступными во время всего периода инкубации до завершения проверки результатов. Сохранить эти данные можно в различных форматах: mp4, PDF, JPG, PNG, BPM, CSV, Excel.
 |
|
Рост бактерий в режиме реального времени |
ПО ScanStation позволяет сохранить изображения фотографий и видео бактериального роста от начала до конца инкубации, которое помогает отслеживать результаты, детектировать отличия между частицей и бактерией на начальном этапе роста колоний, избегая ложные результаты, а также облегчает подсчет плесени.
 |
|
| Преимущества использования ScanStation |
Станция автоматического инкубирования ScanStation 100, Intersience |
|
439100
|
|
|
|
По запросу По запросу |
|
|
|
|||||
|
ScanStation — полностью автоматизированная роботизированная система инкубации, детекции и подсчета колоний на питательном агаре в пластиковых чашках Петри d 90 или 55 мм в реальном времени. Полный цикл анализа системой ScanStation в реальном времени включает в себя инкубацию в термостатируемом шкафу на 100 или 200 чашек в зависимости от модели. В период инкубации каждые 30 минут роботизированное устройство переносит чашку в зону счетчика колоний с камерой высокого разрешения для детекции роста и подсчета колоний микроорганизмов на раннем этапе их развития. Система ScanStation сокращает время получения результатов о количестве колоний микроорганизмов в 3 раза по сравнению со стандартным методом проведения микробиологического анализа. Например, результаты можно получить за 8 часов вместо 24 часов при использовании стандартного метода подсчета: в это время колонии микроорганизмов настолько малы, что сложно уловимы невооруженным глазом человека, но легко распознаются камерой. Характеристики инкубатора и счетчика колоний в реальном времени, системы ScanStation 100, Interscience
|
||||||||||||
|
439200
|
|
|
|
По запросу По запросу |
|
|
|
|||||
|
ScanStation — полностью автоматизированная роботизированная система инкубации, детекции и подсчета колоний на питательном агаре в пластиковых чашках Петри d 90 или 55 мм в реальном времени. Полный цикл анализа системой ScanStation в реальном времени включает в себя инкубацию в термостатируемом шкафу на 100 или 200 чашек в зависимости от модели. В период инкубации каждые 30 минут роботизированное устройство переносит чашку в зону счетчика колоний с камерой высокого разрешения для детекции роста и подсчета колоний микроорганизмов на раннем этапе их развития. Система ScanStation сокращает время получения результатов о количестве колоний микроорганизмов в 3 раза по сравнению со стандартным методом проведения микробиологического анализа. Например, результаты можно получить за 8 часов вместо 24 часов при использовании стандартного метода подсчета: в это время колонии микроорганизмов настолько малы, что сложно уловимы невооруженным глазом человека, но легко распознаются камерой. Характеристики инкубатора и счетчика колоний в реальном времени, системы ScanStation 200, Interscience
|
||||||||||||
|
|
||||||||||||
См. также:
Счетчик колоний, автоматический, черно-белый, размер колоний от 0,1 мм, Scan 300, InterscienceС помощью личного кабинета Вы сможете:
Сравнение